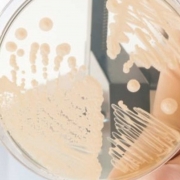

Oregon: A Man’s Fungal Infection Ends in Death
OREGON-A Coos Bay man’s lifelong battle with a rare disease ended Sunday morning.
Brian Baldock, a well-known figure in Marshfield High School athletics, died of a fungal infection at approximately 9:45 a.m. Sunday at Providence St. Vincent Medical Center in Portland. He was 27.
Baldock, who worked for nearly 14 years as the trainer for Marshfield’s football program, was born with chronic granulomatous disease, a condition in which the white blood cells that fight bacterial and fungal infections are missing the enzymes that make them effective.
Baldock’s infection, caused by the common fungus Aspergillus, started in his lungs and rapidly spread into his ribs and spine. It was the same infection he suffered in 1993, when part of his lung and some of his ribs were removed. “It had just spread too much to do that (surgery) now,” Marlene Baldock, Brian’s mother, said Tuesday. “He was too weak to survive a surgery like that.”
Aspergillus is found in the soil as well as in decomposing plant matter, household dust and building material. “It’s everywhere,” Marlene said. “It’s in us, around us and normal people can fight it. It’s a terrible infection; very hard to kill.”
Baldock had been in the hospital several times over the last few months. “He had an infection that just spread so rapidly and through so much of his body we knew he probably wasn’t going to make it out of the hospital this time,” Marlene said. “In the end he just went pretty fast. “The doctor told Marlene and Jerry Baldock, Brian’s father, on Friday that their son wasn’t going to make it and the infection was incurable. Jerry, Marlene, Brian’s girlfriend Kayla Schmidt and her mother were with him when the doctor broke the news.
What the doctor had to say was a sharp contrast from what Baldock’s loved ones told him his entire life. “That was probably the hardest part of all was just having to tell Brian,” Marlene said. “We’ve never thought that way. We’ve always had hope, just lots of hope, that he would get through this.” The family always had believed Baldock would live to see a cure. He participated in a protocol program with National Institutes of Health in Washington, D.C., to help find a remedy for his particular disease.
Baldock, Marlene indicated, was just as courageous at the end as he was his entire life. “He was scared; he knew,” Marlene said. “Things just kept progressing and he couldn’t stay ahead of the game. Of course every time he got sick over the years, it took a little bit out of him.” Last weekend, Baldock had fought as hard and as long as he could. “He just didn’t have the strength to fight it any more, but he never gave up,” Marlene said. “He never gave up.”
Marshfield football coach Kent Wigle said Baldock was a veteran trainer who began working with the Pirates in 1991 as a high school freshman. “Essentially he’s been helping us in some capacity since then,” Wigle said. “That whole time he was fighting for existence.” Wigle described Baldock as the perennial team player who always wanted to see the organization be successful.
Baldock was more than a trainer to the hundreds of Pirate football players who passed through the program in the last 14 years. Many players called him “coach” and heeded his advice about how they should conduct themselves on the football field and in life. Baldock formed close bonds with many athletes over the years. “A lot of young men have learned a great deal by seeing all the trials and tribulations he went through in his life,” Wigle said. “He touched a lot of lives. I’m including players and coaches in that.”
Baldock was surrounded by close friends – mostly from his 1995 senior class at Marshfield – right up until the end. Most of his closest friends were involved with Pirate football in their high school years.
CGD patients can fight viral infections, but are susceptible to staphylococcal and other infections. An average person gets sick once out of 50 exposures to bacteria or fungus. For a CGD patient, it takes just two or three exposures. Baldock was one of only about 648 people in the world registered with the disease, and the only one in Oregon. Initially, Baldock wasn’t expected to reach age 5. Then the estimate became 10; then 20. But the man who stood about 5 feet, 3 inches tall and weighed about 100 pounds made a life out of defying the odds. He was hooked up to oxygen for the past few years and underwent dialysis treatments regularly to make up for his kidneys, which were destroyed by the anti-fungal medication he took for most of his life.
Even in their grief, Baldock’s family and those who knew him best say they are relieved in a sense that Baldock’s pain and suffering has ended. “A person can only take so much and he took a lot,” Marlene said. “He had so many friends and he just loved the kids at the high school. We think all in all, in spite of what he went through, he had a high quality life.”

 ©Stern Mold
©Stern Mold 
 Indoor Science
Indoor Science www.moldfreeliving.com
www.moldfreeliving.com 



